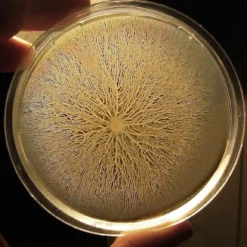
ToshiFarm Petrischaal - 5 Stuks - Petrischalen Met Agar - Steriele Petrischaal Met Agar - Steriele Agar Plaatjes 9 ToshiFarm Petrischaal - 5 Stuks - Petrischalen Met Agar - Steriele Petrischaal Met Agar - Steriele Agar Plaatjes -Goedkope Groene Liefde Winkel 1200x1155 1

Een set van 5 steriel afgesloten petrischaaltjes met Kimmig Agar in een steriele bundelverpakking. Kimmig Fungal Agar wordt gebruikt voor het isoleren en kweken van schimmels uit klinische exemplaren. Een petrischaal met agar is een niet-selectief medium dat de ontwikkeling van de karakteristieke eigenschappen van mycelium toestaat. Kimmig Agar kan ook worden gebruikt voor de teelt van gisten. De relatief lage pH van de Agar is zeer gunstig voor schimmels: op dit medium worden bacteriën slechts zeer weinig geremd. De petrischalen zijn steriel verpakt en dienen ook als zodanig te worden behandeld om infectie van het Agar te voorkomen.
- Bewaartemperatuur: 2-8 °C (voorkom bevriezing en oververhitting)
- Incubatietemperatuur: 37 °C
- Niet blootstellen aan (direct) zonlicht

Beoordelingen
Er zijn nog geen beoordelingen.